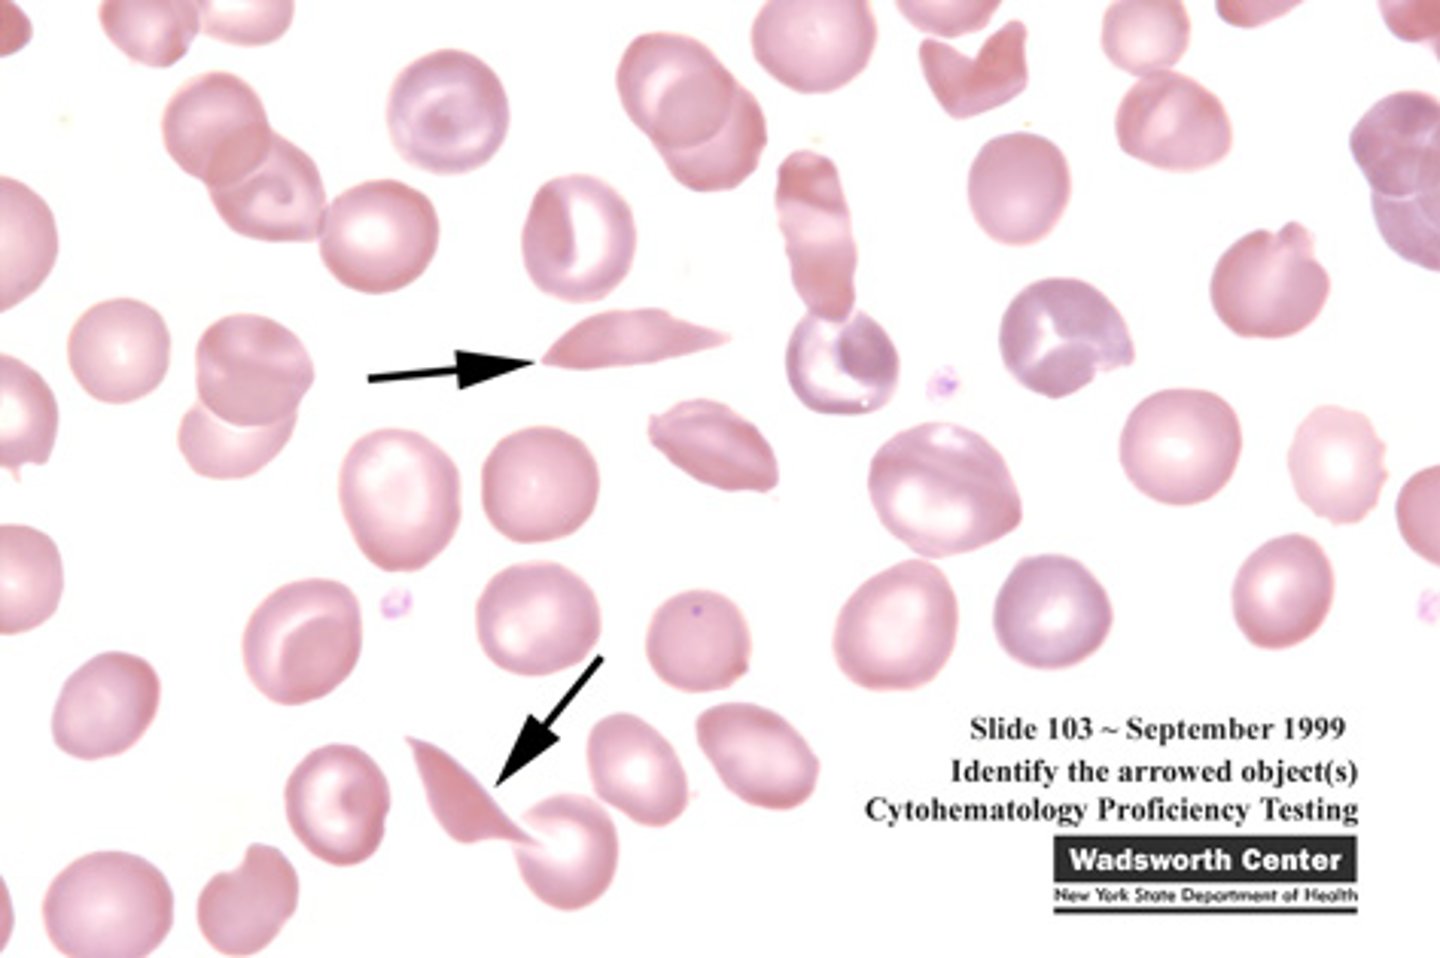
<p>Mutations in the beta-globin gene (HBB gene) in chromosome 11 will manifest to _____.</p>

1/64
Looks like no tags are added yet.
Name | Mastery | Learn | Test | Matching | Spaced | Call with Kai |
|---|
No analytics yet
Send a link to your students to track their progress
Codominance
When two dominant alleles are present, both alleles will be expressed when combined.
Codominance
Absence of a recessive allele.
Roan
Red and white hairs are expressed equally.

Codominance
Inheritance of the MN blood antigen (a glycoprotein found on the surface of red blood cells in humans) involves _____.
Codominance
Two traits come out.

Capitalized
Letters used for the punnett square in codominance should be _____, since only two dominant alleles are present.

Incomplete dominance
When dominant alleles are absent, only a recessive allele will combine with another recessive allele.
Incomplete dominance
"The pattern of inheritance, where an intermediate phenotype other than the two parental phenotypes, is observed."
Incomplete dominance
The offspring does not resemble either of the parents.
Incomplete dominance
Absence of a dominant allele.
Incomplete dominance
Two traits are blended.
Lowercase and use a superscript
Letters used for the punnett square in incomplete dominance should be in _____ and use a _____, since only two recessive alleles are present.
Multiple alleles
When more than two alleles exist in a certain character.

Antigen
Substances that can trigger immune responses if foreign to body (e.g., A, B, O, AB).
O
Universal donor blood type that can only receive blood from its own blood type. Carry only the __ genotype.
AB
Universal receiver blood type that can only donate blood to its own blood type. Carry only the __ genotype.
Rhesus (Rh) factor
An inherited protein found on the surface of red blood cells. If your blood has the protein, you're Rh positive. If your blood lacks the protein, you're Rh negative.
Rh positive
The most common blood type.
+
The symbol indicating the presence of the protein Rh factor found in blood types (e.g., A+, B+, AB+, O+).
-
The symbol indicating the lack of the protein Rh factor found in blood types (e.g., A-, B-, AB-, O-).

Multiple alleles
Inheritance of ABO blood types in humans involves _____.
Agglutinogens
Also known as A and B antigens. Found on the surface of RBCs in humans and are used as the most common means of blood typing.
Agglutinin (Antibodies)
The presence of agglutinogens causes the formation of _____, a substance that makes particles coagulate.
Lethal genes
A condition when a certain combination of alleles will result to death of the carrier.
Albinism
Absence of chlorophyll in green plants will lead to _____, which is lethal to the carrier because of the inability to undergo photosynthesis.
Polygenic inheritance
Traits that are controlled by two or more genes (e.g., in humans: skin color, height, intelligence quotient, eye color).
Polygenes
Genes involved in polygenic inheritance, often found in different chromosomes.
Sex-linked Inheritance
Inheritance of genes located in the sex chromosomes.
X chromosome
A submetacentric chromosome having an arm shorter than the other, with roughy 156 million base pairs of DNA containing approximately 800 protein-coding genes.

Y chromosome
A relatively smaller telocentric chromosome with about 57 million base pairs of DNA containing approximately 63 protein-coding genes.

XX chromosome
Female.
XY chromosome
Male.
Color blindness
An inherited sex-linked disease in humans characterized by decreased ability to see color differences.
Color blindness
This is caused by a mutation in genes that produce red and green light-sensitive proteins in the X chromosome.
Recessive X-linked gene
Color blindness is inherited as a _____ gene, thus, it affects males more frequently than females.
Ishihara test
A common color perception test to determine color blindness in a person.

Ishihara test
The test consists of pseudoisochromatic plates (PIP) that contains dots that appear random sizes and colors.

Dr. Shinobu Ishihara
Developed the Ishihara Test in 1917 at the University of Tokyo.
Hemophilia A
A genetic disorder caused by missing or defective factor VIII, a clotting protein. Although it is passed down from parents to children, about 1/3 of cases are caused by a spontaneous mutation, a change in a gene.
Factor VIII (FVIII) deficiency or classic hemophilia
State the other terms for Hemophilia A:
Carrier
A female parent who possesses one X-linked recessive mutation is considered a _____. They will not manifest clinical symptoms of the disorder but will pass on the trait to the next generation.
Sex-influenced Inheritance
Refers to autosomal traits whose expression of dominance is affected by the sex of the individual. Follows the Mendelian pattern of dominance and recessiveness. However, the effect in one sex is dominant whereas it is recessive in another sex.
Autosomal
A specific gene is not on a sex chromosome (X and Y) and is a numbered chromosome (pairs 1-22).
Male-pattern baldness
The expression of baldness is influenced by the testosterone,which explains the higher frequency of baldness in males compared to females
Males; Females
Hairlip and Gout is more dominant in _____ than _____.

Females; Males
Spina bifida is more dominant in _____ than _____.
Hairlip
Cleft lip.

Gout
A type of arthritis.

Spina bifida
Congenital defect of the spine in which part of the spinal cord and its meninges are exposed.

Pleiotropy
A condition when one gene causes several effects (multiple traits) in various organs of the body.

Pleiotropy
Will then result to syndrome, which is a group of symptoms that may appear simultaneously, an indication of a particular genetic mutation.
Marfan syndrome; Porphyria; Phenylketonuria; Albinism; Autism; Schizophrenia
Enumerate six (6) examples of Pleiotropy:
MPPAAS
Sickle cell anemia
Mutations in the beta-globin gene (HBB gene) in chromosome 11 will manifest to _____.
Pedigree analysis
Symbols are used to represent members and relationships in a family being analyzed.

Normal male
Unshaded square.

Afflicted male
Shaded square.

Normal female
Unshaded circle.

Afflicted female
Shaded circle.

Unknown sex
Unshaded diamond.
Heterozygote

Fraternal twins

Identical twins

Marriage (related)

Generation no.
I, II, III
Offspring no.
1,2,3